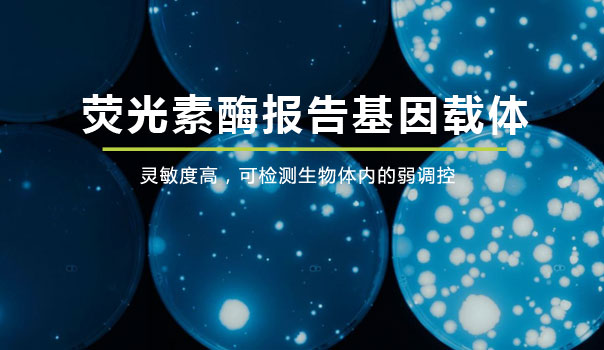

蛋白組/代謝組
- 定量蛋白質(zhì)組學(xué)
- DIA非標(biāo)定量

- Label free非標(biāo)定量

- TMT標(biāo)記定量

- PRM靶向定量
- Western Blot
蛋白/核酸相互作用
- RNA-蛋白/RNA互作
- RNA pull down

- circRNA pull down

- miRNA pull down

- RIP

- DNA-蛋白互作
- DNA pull down

- ChIP (染色質(zhì)免疫共沉淀)

- 化合物-蛋白互作
- 化合物pull down

細(xì)胞株構(gòu)建
- 表達(dá)細(xì)胞株
- 基因表達(dá)穩(wěn)轉(zhuǎn)株構(gòu)建(轉(zhuǎn)座子)
- 基因表達(dá)穩(wěn)轉(zhuǎn)株構(gòu)建(慢病毒)
- 抗體表達(dá)穩(wěn)轉(zhuǎn)株(CHO細(xì)胞)
- 敲除細(xì)胞株
- 基因敲除單克隆株(Crispr-cas9)
分子/細(xì)胞生物學(xué)
- 分子生物學(xué)
- 基因調(diào)取/合成(cDNA克隆)
- 載體構(gòu)建
- 熒光定量PCR (qPCR)

IP / Pull down Beads
一抗
分子互作試劑盒


 實(shí)驗(yàn)熱線:4006991663
實(shí)驗(yàn)熱線:4006991663